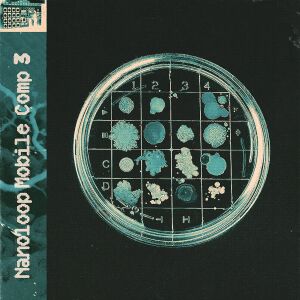
Обложка

Ссылки
Трек-лист
- Larix decidua - Intro
- 8rix - Another Atom Train
- EMF5 - Polymeric Blood
- eVADE - Mond He
- Gesceap - Distfree
- glooms - Time Vortex
- Kasai Takara - Falling Apple
- Luce - Reflections
- Notehead - Para-Slug
- Ray N. - Kling
- spoody - Grind
- sylcmyk - Saltkisser
- Larix decidua - Outro